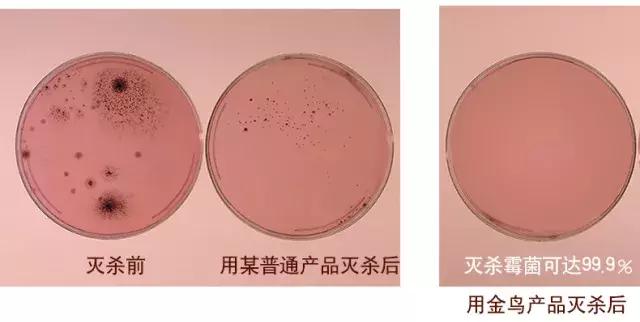
霉菌感染用什么喷雾比较好,潮湿的霉菌用什么消毒比较好

刚送走湿漉漉的“回南天”,家里的湿气还弥漫着久久未散去。回想起那段时间墙壁冒水,玻璃起雾,地板湿乎乎,家里哪儿哪儿都是一股湿湿臭臭的感觉……


趁着最近的大太阳,家里能搬动的都搬出去晒了晒。但要命的是衣服上的霉渍、书上的“斑点”,还有墙上种种痕迹……看着都心累!




想着再过两个月的梅雨季——拖不干的地,晾不干的衣服,还有家里散不去的湿臭味,我内心充满了绝望……

直到发现了这款神器——日本金鸟杀菌消毒除臭防霉喷雾,讲真,只需喷一喷,霉渍没了,异味也没了!

家里霉菌对人体有哪些危害?
1、长期接触和吸入霉菌, 可引发呼吸道疾病和过敏症状等,例如支气管炎、扁桃体炎、花粉热、哮喘病等;
2、免疫力低的人可能因此引起头疼、发烧、皮肤或黏膜发炎、中毒,或产生致癌物质;
3、引起霉菌性肺炎等疾病;
4、引起其他过敏性疾病。

根据国家卫生与医学研究所证实:研究人员对 1100名成年哮喘患者进行研究后发现,对霉菌过敏的患者要比对其他物质过敏的患者高5倍。
造成发霉现象的霉菌,不仅会释放出过敏物质,引发过敏,霉菌中还隐藏大量肝炎病毒、流感病毒等,有些还会引起严重的肺部病变,甚至死亡。

据世界卫生组织调查显示,家庭霉菌在世界各国80%以上的家庭都有不同程度的存在。我国因气候条件、建筑质量及家庭环境等众多因素的影响,家庭霉菌的污染状况要远远高于其他国家。

这款防霉除臭喷雾有什么神奇功效?
一、防霉
其实不止春夏时节需要防霉哦,平时我们的住宅密封性很高,而且冬天会使用暖气和加湿器,都会造成窗户上的湿气结成水珠滴到窗帘上,造成窗帘湿漉漉,进而霉菌也很容易滋生,所以防霉不分时节哦~
市面上许多防霉产品成分巨多且杂,让人看的眼花缭乱云里雾里,其实这种产品并不是成分越多越好,有效才是硬道理。
这款*剂喷**中的防霉剂,在分解霉菌后形成防霉保护层,从源头抑制霉菌生长,达到99.9%有效防霉!

二、祛味
平时房间内的窗帘上,经常有香烟气味和烹饪臭味等,时间久了气味混合比较多,就会产生难闻的味道。面对这样的的气味,我们可以直接用喷雾喷在窗帘上,过一会挥发到空气中,就能达到除臭祛味的效果!
这款*剂喷**中含有的天然植物除臭成分,能够有效的消除异味、净化空气,让你随时在家都能呼吸到新鲜空气!

常见的空气清新剂大多由乙醇、香精、去离子水等组成,装罐的时候又加入丙烷、丁烷、二甲醚等化学成分。这些物质本来就是具有挥发性的有毒物质,一旦打开使用,释放到空气中被人体吸收,就会刺激人的呼吸道黏膜,容易引发各种呼吸系统疾病,如若长期使用,会造成慢性中毒。

金鸟的这款消臭*剂喷**中的植物成分,不会刺激呼吸道,净化空气的同时,也能为你的健康保驾护航哦!
三、消毒
*剂喷**中的有效因子,可以迅速分解霉菌孢子,阻断霉菌繁殖。除霉菌外,还可以杀灭其他类型的众多细菌病毒。

这款天然成分的喷雾,比单纯的消毒剂功效更多还更安全哦~

使用方法

建议使用前先戴上口罩,用干毛刷弹掉霉点(或用浸有酒精的抹布将霉点擦除);
之后直接喷上本品,喷射口前端需对准ON ,距离20cm使整体湿润;

用完后喷雾口归位在OFF,等待晾干。

适用范围
本品可以使用在霉菌存在较多的地方,如:潮湿墙面、墙角、卫生间、地板及瓷砖缝隙、窗台边缘、家居沙发、汽车内饰、衣柜橱柜内外、水池周围及菜板上面等。




品牌介绍

日本金鸟(KINCHO)成立于1885年,是日本及世界著名、历史悠久的家庭清洁卫生杀虫公司,是世界家庭卫生杀虫领域的开创者。日本金鸟在世界上第一个发明盘状蚊香,蟑螂诱饵剂,电子液体蚊香,驱蚊虫清香剂,无味防蛀剂,天然除螨剂,防蚊网等等,日本金鸟一直引领着世界家庭卫生杀虫的方向。

日本金鸟在总部大阪拥有最大最好的卫生杀虫中央研究院,在世界各地拥有7家分公司,6家工厂,是日本家喻户晓的国民品牌。

金鸟是一家立足于自然与生活之间的公司,为了将更加安全、放心的产品交到消费者手中,金鸟建立起万全的质量管理体系。

金鸟还建立有自己的生产线,通过日常的抽样测试,从有效成分、功能、外观检查等各个方面实施产品检查。而且,在各工厂设立的研究室中,进行成分提取和分析等,根据分析数据构筑起严格的质量管理体系。

金鸟还把握商品整体的流通情况,努力实现商品的稳定供给。不仅追求效率,对质量的追求也丝毫未懈怠。为了回报顾客的深厚信赖,金鸟保证向顾客家庭提供的商品质量会更优。
产品详情

这款消臭防霉*剂喷**容量有300ml,家里窗帘、壁纸、汽车内饰、厨房各角落平时都可以喷一喷,无异味、不刺鼻,300ml怎么喷都不心疼,保质期三年放心使用哦!

注意:真丝及绸缎等尽量不接触水的制品,蜡、漆、白木、铜、塑料制品、皮革制品、皮草等,不可使用。
